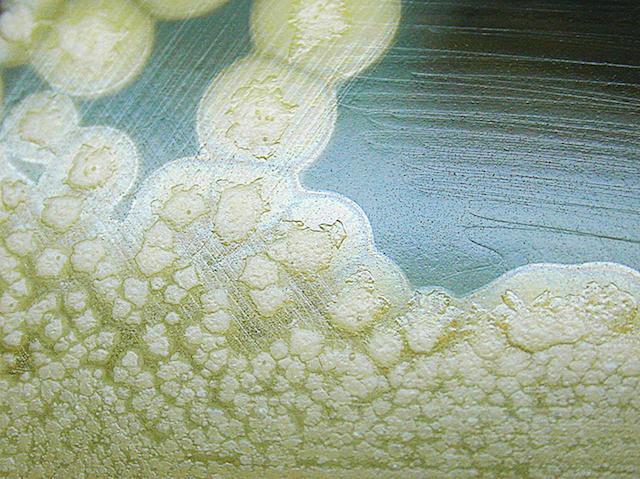

26 June 2017
Notox
This is a culture of Clostridium botulinum bacteria, which produce one of the most poisonous biological substances known to man. The incredibly potent botulinum neurotoxin is responsible for the sometimes-fatal food-borne disease, botulism – characterised by muscle weakness and paralysis – (as well as the perfectly smooth, wrinkle-free foreheads of age-defying celebrities). Because of the toxin’s potency, lethality, and ease of production, it is categorised as a bioterrorism threat on par with anthrax, plague, or Ebola. But now scientists have serendipitously discovered a potential antidote. While using a special chemical synthesis, called click chemistry, to create novel compounds that might inhibit the toxin, the researchers found that one of the synthesis reagents, rather than the actual compounds, could block the toxin. They went on to test the reagent – copper chloride – in mice given lethal doses of the toxin and found that the treatment could significantly extend the animals lives.
Written by
Search The Archive
Submit An Image
Like us on Facebook
Follow on Twitter
Follow on Tumblr
Follow on Instagram
What is BPoD?
BPoD stands for Biomedical Picture of the Day. Managed by the MRC Laboratory of Medical Sciences until Jul 2023, it is now run independently by a dedicated team of scientists and writers. The website aims to engage everyone, young and old, in the wonders of biology, and its influence on medicine. The ever-growing archive of more than 4000 research images documents over a decade of progress. Explore the collection and see what you discover. Images are kindly provided for inclusion on this website through the generosity of scientists across the globe.
BPoD is also available in Catalan at www.bpod.cat with translations by the University of Valencia.








